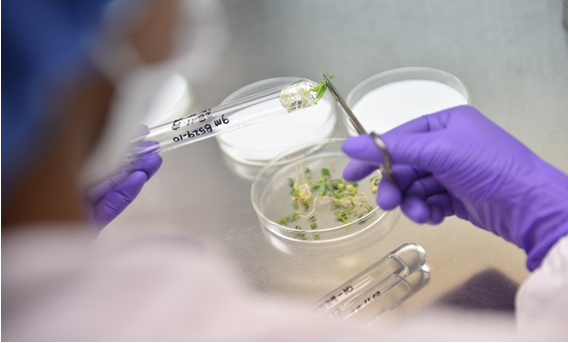

Các biện pháp canh tác nông học nhằm nâng cao giá trị dinh dưỡng của cây trồng thực phẩm

Các biện pháp canh tác đóng vai trò then chốt trong việc nâng cao giá trị dinh dưỡng của cây lương thực và góp phần khắc phục tình trạng thiếu vi chất dinh dưỡng trong khẩu phần ăn của con người. Quản lý phân bón là một trong những hướng tiếp cận quan trọng trong lĩnh vực này. Nguồn: Adobe Stock/oticki.
Việc cải thiện giá trị dinh dưỡng của cây lương thực có ý nghĩa đặc biệt quan trọng trong nỗ lực giải quyết tình trạng thiếu hụt vi chất dinh dưỡng trên toàn cầu. Những chiến lược như tăng cường dinh dưỡng sinh học, chọn tạo giống và áp dụng các biện pháp canh tác tiên tiến có thể góp phần nâng cao hàm lượng dưỡng chất trong các loại cây lương thực chủ yếu. Sinh lý học thực vật, đặc biệt là cấu trúc bộ rễ, khả năng hấp thu và vận chuyển dinh dưỡng, có ảnh hưởng trực tiếp đến quá trình tích lũy vitamin và khoáng chất thiết yếu. Trong khi đó, các kỹ thuật canh tác như bón phân cân đối, phun phân qua lá, quản lý độ phì đất, bổ sung chất hữu cơ, và ứng dụng nông nghiệp chính xác có thể nhanh chóng và hiệu quả cải thiện chất lượng dinh dưỡng của cây trồng. Cuối cùng, việc kết hợp đồng bộ các hướng tiếp cận này mang lại giải pháp khả thi và có thể mở rộng, giúp giảm thiểu tình trạng “đói tiềm ẩn”, cải thiện sức khỏe cộng đồng, đồng thời thúc đẩy phát triển các hệ thống canh tác bền vững và có khả năng thích ứng cao trên toàn cầu.
Dinh dưỡng đầy đủ là yếu tố nền tảng đối với sự tăng trưởng, phát triển và sức khỏe con người. Các dưỡng chất chính bao gồm các axit amin thiết yếu; axit béo; vitamin; các khoáng chất đa lượng như canxi, phốt pho, magiê, natri và kali; các khoáng chất vi lượng như sắt, kẽm, đồng và i-ốt; cùng các hợp chất thiết yếu khác. Dinh dưỡng đầy đủ cung cấp các chất đa lượng và vi lượng cần thiết để xây dựng và duy trì các mô, giúp cơ thể phát triển bình thường và duy trì các chức năng sinh lý (Savarino và cs., 2021). Các dưỡng chất này cũng góp phần định hình khả năng kháng bệnh. Nhiều loại vitamin và khoáng chất (đặc biệt là vitamin C, vitamin D và kẽm) hỗ trợ hệ miễn dịch bẩm sinh và miễn dịch thích ứng, và ngay cả những thiếu hụt nhẹ cũng có thể làm suy giảm chức năng miễn dịch (Gombart và cs., 2020).
Mặc dù thế giới đã đạt được những bước tiến đáng kể trong việc giảm đói nghèo, với tỷ lệ toàn cầu giảm 13%, nhưng một vấn đề khác ít được chú ý hơn song cũng nghiêm trọng không kém vẫn đang tồn tại (UNICEF, WHO & World Bank, 2023). Hàng tỷ người hiện nay đang phải đối mặt với tình trạng “đói tiềm ẩn”, khi khẩu phần ăn có thể cung cấp đủ năng lượng nhưng lại thiếu các vitamin và khoáng chất thiết yếu. Cuộc khủng hoảng dinh dưỡng này ảnh hưởng đến khoảng một phần ba dân số thế giới, cao hơn nhiều so với 735-795 triệu người đang thiếu lương thực mỗi ngày (FAO và cs., 2023).
Quy mô của tình trạng suy dinh dưỡng thật đáng báo động: 2,5 tỷ người trưởng thành bị thừa cân và 890 triệu người béo phì, trong khi 390 triệu người vẫn thiếu cân (WHO, 2024). Ngoài tác động đến sức khỏe con người, cuộc khủng hoảng này còn gây ra tổn thất kinh tế to lớn, khi tình trạng thiếu dinh dưỡng và thiếu vi chất làm giảm năng suất lao động toàn cầu khoảng 1 nghìn tỷ USD mỗi năm (FAO, 2013).
Thiếu vi chất dinh dưỡng hiện là một trong những thách thức sức khỏe cộng đồng phổ biến nhất hiện nay. Các vi chất bị thiếu hụt nghiêm trọng nhất bao gồm vitamin A, vitamin D, vitamin B12, sắt, i-ốt và kẽm (Weffort và cs., 2024). Các nghiên cứu gần đây cho thấy hơn một nửa dân số thế giới tiêu thụ lượng vi chất thấp hơn mức khuyến nghị, bao gồm canxi, sắt và nhiều loại vitamin quan trọng (Passarelli và cs., 2024). Thiếu sắt, kẽm và vitamin A làm suy yếu hệ miễn dịch, giảm năng suất lao động và gia tăng tỷ lệ tử vong (Bailey và cs., 2015). Tại Hoa Kỳ, cứ bốn phụ nữ mang thai thì có một người bị thiếu sắt, trong khi hơn một nửa trẻ em dưới năm tuổi trên toàn cầu không được cung cấp đủ vitamin và khoáng chất (CDC, 2025). Tình hình ở các quốc gia có thu nhập thấp và trung bình còn đáng lo ngại hơn, khi hơn một nửa số thiếu nữ và phụ nữ trẻ không đáp ứng được nhu cầu vi chất dinh dưỡng cơ bản (UNICEF, 2021).
Trước quy mô của cuộc khủng hoảng dinh dưỡng toàn cầu, việc nâng cao giá trị dinh dưỡng của cây lương thực được xem là một giải pháp đầy hứa hẹn và có thể mở rộng. Dù không có loại thực phẩm nào có thể cung cấp đầy đủ mọi dưỡng chất, song việc cải thiện có chiến lược hàm lượng dinh dưỡng của các cây trồng được tiêu thụ phổ biến có thể giúp thu hẹp khoảng cách dinh dưỡng thiết yếu trên toàn thế giới.
Tăng cường giá trị dinh dưỡng
Tăng cường giá trị dinh dưỡng đề cập đến tập hợp các chiến lược nhằm cải thiện hàm lượng dưỡng chất của cây lương thực thông qua việc gia tăng các chất dinh dưỡng đa lượng và vi lượng thiết yếu, đồng thời giảm thiểu các yếu tố phản dinh dưỡng. Việc nâng cao chất lượng dinh dưỡng của các cây lương thực chủ yếu cũng như những loại thực phẩm được tiêu thụ phổ biến khác là một bước quan trọng trong nỗ lực giải quyết tình trạng thiếu hụt dinh dưỡng lan rộng ở Hoa Kỳ và trên toàn cầu. Nhiều phương pháp khác nhau như tăng cường dinh dưỡng sinh học, cải tiến di truyền, biện pháp canh tác và xử lý sau thu hoạch có thể được áp dụng nhằm đạt được mục tiêu nâng cao bền vững giá trị dinh dưỡng của cây trồng.
Tăng cường dinh dưỡng sinh học là một hình thức tăng cường giá trị dinh dưỡng, tập trung chủ yếu vào các vi chất như khoáng chất và vitamin (Bouis và cs., 2024). Một trong những chương trình tăng cường dinh dưỡng sinh học quan trọng nhất là HarvestPlus, được điều hành bởi Viện CGIAR, chuyên phát triển, thử nghiệm và mở rộng quy mô các giống cây trồng được tăng cường dinh dưỡng thuộc 12 loại cây lương thực chủ yếu, qua đó cải thiện chế độ ăn của hàng trăm triệu người (Hình 1). Chương trình HarvestPlus tập trung vào các vi chất quan trọng bằng cách phát triển khoai lang, ngô và sắn giàu vitamin A; đậu và kê cườm giàu sắt; cùng lúa và lúa mì giàu kẽm (Van Der Straeten và cs., 2020). Tính đến năm 2022, chương trình đã chính thức phát hành hơn 445 giống cây tăng cường dinh dưỡng tại 40 quốc gia, tiếp cận hơn 100 triệu người, góp phần cải thiện tình trạng dinh dưỡng, đặc biệt là đối với phụ nữ và trẻ em (Bouis và cs., 2024).
![]()

Hình 1. Lúa (trái) và lúa mì (phải) là những cây trồng mục tiêu của các chương trình tăng cường giá trị dinh dưỡng như HarvestPlus, chương trình phát triển và phổ biến các giống cây được tăng cường kẽm nhằm cải thiện chất lượng khẩu phần ăn. Các chiến lược canh tác và di truyền được thực hiện trên đồng ruộng, kết hợp với các thí nghiệm về quản lý dinh dưỡng, góp phần nâng cao giá trị dinh dưỡng của những cây lương thực chủ yếu này. Ảnh bên trái: HarvestPlus. Ảnh bên phải: Sofia Cominelli, nghiên cứu sinh sau đại học, Đại học Bang Kansas.
Hiểu biết sinh lý học phục vụ cải thiện giá trị dinh dưỡng của cây trồng thực phẩm
Việc nâng cao giá trị dinh dưỡng trong cây trồng thực phẩm đòi hỏi hiểu rõ cách cây hấp thu và phân bố dinh dưỡng thông qua ba giai đoạn chủ yếu: (i) hấp thu khoáng chất và nước bởi rễ, (ii) vận chuyển đường dài qua mạch gỗ (xylem) và mạch rây (phloem), và (iii) phân phối có định hướng đến các cơ quan cụ thể của cây.
Cấu trúc hệ rễ đóng vai trò nền tảng trong khả năng hấp thu dinh dưỡng. Sự biến dị trong hình thái và cấu trúc rễ ảnh hưởng đáng kể đến hàm lượng kẽm, sắt, protein và các chất dinh dưỡng khác trong hạt và quả (Noor et al., 2024; Amiri et al., 2015; Sultana et al., 2023). Hệ rễ phát triển mạnh giúp gia tăng diện tích tiếp xúc và hiệu quả huy động dinh dưỡng. Ví dụ, các nguồn vật liệu di truyền hoang dại như Triticum polonicum với hệ rễ phát triển đã được xác định là nguồn gen có giá trị trong chọn tạo nhằm nâng cao hàm lượng các khoáng chất thiết yếu như đồng, magiê, selen và kẽm (Bieńkowska et al., 2019). Bên cạnh đó, các nguồn gen này còn chứa hàm lượng cao hơn các hợp chất phenolic, flavonoid và carotenoid trong hạt, là những đặc điểm có thể được chuyển giao vào các giống lúa mì ưu tú để cải thiện chất lượng dinh dưỡng (Suchowilska et al., 2020).

Cấu trúc hệ rễ giữ vai trò nền tảng trong khả năng hấp thu dinh dưỡng của cây. Hình minh họa được điều chỉnh từ Hình 1 trong bài báo “Constitutive basis of root system architecture: uncovering a promising trait for breeding nutrient- and drought-resilient crops” của Liu và cs. (2023), theo giấy phép CC BY 4.0.
Ngoài ra, các đặc tính hình thái rễ được cải thiện, chẳng hạn như mạch gỗ có đường kính lớn hơn và mô mềm mạch rây phát triển trong rễ, cũng có liên quan đến hàm lượng khoáng chất và chất chống oxy hóa cao hơn ở nhiều loài cây trồng, từ nho đến cà rốt (Klimek et al., 2022; Zhao et al., 2025). Bên cạnh đó, gốc ghép cũng là nguồn vật liệu quan trọng trong việc nâng cao hàm lượng hợp chất phenolic, chất chống oxy hóa, cũng như cải thiện chất lượng quả ở cây nho (Ozden et al., 2010; Cheng et al., 2017). Những phát hiện này cho thấy cấu trúc hệ rễ có thể được xem là một đặc tính chọn lọc tiềm năng nhằm nâng cao giá trị dinh dưỡng của cây trồng thực phẩm.
Sau khi được hấp thu, các chất dinh dưỡng được vận chuyển khắp cơ thể cây thông qua các mô dẫn - mạch gỗ và mạch rây. Hiệu quả của quá trình vận chuyển đường dài trong các mô này có ảnh hưởng đáng kể đến hàm lượng khoáng chất trong hạt và quả (Braun et al., 2014). Ngoài ra, các nguyên tố vi lượng được chuyển đến hạt thông qua tế bào sàng nhờ liên kết qua plasmodesmata (Patrick & Offler, 2001). Ví dụ, sắt được tích lũy vào hạt lúa mì thông qua quá trình vận chuyển bằng mạch rây (Garnett & Graham, 2005; Grillet et al., 2014).
Quá trình hấp thu và phân bố khoáng chất được điều hòa bởi các kênh ion và protein vận chuyển màng trong mô rễ và thân. Các nhóm gen vận chuyển chủ chốt có vai trò nâng cao hàm lượng vi lượng trong mô thực vật bao gồm: protein ZIP vận chuyển kẽm và sắt, protein NRAMP vận chuyển kim loại hóa trị hai và protein HMA vận chuyển ngược ion kim loại ra ngoài tế bào (Hussain et al., 2004; Nevo & Nelson, 2006; Ajeesh Krishna et al., 2020). Việc điều chỉnh các hệ thống vận chuyển này thông qua chọn giống hoặc kỹ thuật di truyền được xem là chiến lược tiềm năng để cải thiện hàm lượng vi lượng trong hạt và quả. Ví dụ, sự biểu hiện quá mức các gen vận chuyển ZIP đã làm tăng đáng kể hàm lượng kẽm tích lũy trong lúa và lúa mì, qua đó minh chứng tiềm năng của chiến lược tăng cường dinh dưỡng dựa trên hệ thống vận chuyển (Lee et al., 2010; Li et al., 2021).
Các hướng tiếp cận nhằm nâng cao giá trị dinh dưỡng của cây trồng thực phẩm
Có nhiều phương pháp khác nhau để cải thiện giá trị dinh dưỡng của cây trồng thực phẩm. Các chiến lược này bao gồm biện pháp quản lý canh tác, chọn giống truyền thống, và kỹ thuật di truyền, trong đó việc lựa chọn phương pháp phụ thuộc vào loài cây trồng, nguyên tố hoặc dưỡng chất mục tiêu, cũng như điều kiện môi trường và đất đai (Bouis & Saltzman, 2017; Garg et al., 2018). Đối với người nông dân, cây trồng không chỉ cần có hàm lượng dinh dưỡng cao, mà còn phải cho năng suất tốt và chịu được các yếu tố gây stress sinh học và phi sinh học. Do đó, khi tập trung nâng cao giá trị dinh dưỡng, cũng cần đồng thời xem xét các yếu tố này để đảm bảo các giống và công nghệ mới có thể được nông dân dễ dàng chấp nhận và áp dụng.
Chọn giống truyền thống là một chiến lược hiệu quả về chi phí, bền vững và dài hạn nhằm cải thiện giá trị dinh dưỡng của cây trồng thông qua việc phát triển các giống có hàm lượng khoáng chất và dưỡng chất thiết yếu cao hơn. Tuy nhiên, phương pháp này đòi hỏi thời gian dài và hiệu quả của nó chịu ảnh hưởng mạnh bởi điều kiện môi trường cũng như nền tảng di truyền của cây trồng.
Chú thích: ©2017 CIAT/Neil Palmer. Giấy phép CC BY-NC-SA 2.0.
Các phương pháp chuyển gen cung cấp một hướng tiếp cận thay thế, đặc biệt hữu ích trong những trường hợp nguồn biến dị di truyền tự nhiên đối với các nguyên tố dinh dưỡng cụ thể còn hạn chế hoặc không tồn tại trong loài. Các kỹ thuật này cho phép chuyển nạp các gen có lợi từ loài khác hoặc chỉnh sửa chính xác các gen mục tiêu nhằm tăng hàm lượng dinh dưỡng, cải thiện khả năng hấp thu sinh học và giảm hàm lượng các hợp chất kháng dinh dưỡng trong cây trồng.
Ngược lại, các biện pháp nông học được xem là chiến lược thực tiễn và có tốc độ ứng dụng nhanh hơn, dựa trên việc tối ưu hóa liều lượng, thời điểm và phương pháp bón phân. Các kỹ thuật phổ biến bao gồm bón phân vào đất, phun qua lá, xử lý hạt giống bằng dinh dưỡng và canh tác thủy canh. Mặc dù những phương pháp này có thể được áp dụng rộng rãi cho nhiều loại cây trồng và đòi hỏi ít nguồn lực cũng như thời gian hơn so với chọn giống, song hiệu quả của chúng vẫn phụ thuộc đáng kể vào điều kiện môi trường, đồng thời cần có quản lý chặt chẽ để giảm thiểu thất thoát dinh dưỡng và rủi ro đối với môi trường.
Các biện pháp nông học nhằm nâng cao giá trị dinh dưỡng của cây trồng
Các biện pháp nông học đóng vai trò then chốt trong việc nâng cao giá trị dinh dưỡng của cây trồng thực phẩm và góp phần khắc phục tình trạng thiếu vi chất dinh dưỡng trong khẩu phần ăn của con người. Trước đây, quản lý dinh dưỡng cây trồng chủ yếu tập trung vào mục tiêu năng suất, tuy nhiên, ngày càng có nhiều bằng chứng cho thấy việc quản lý tổng hợp giữa dinh dưỡng đa lượng và vi lượng có thể làm tăng hàm lượng dinh dưỡng trong sản phẩm thu hoạch. Các hướng tiếp cận quan trọng bao gồm quản lý phân bón, tối ưu hóa đất và vùng rễ, bón dinh dưỡng qua lá, nông nghiệp chính xác và quản lý cây trồng tổng hợp.
Quản lý phân bón

Hình 2. Hình ảnh cho thấy cây ngô ở giai đoạn trỗ cờ - phun râu trong một thí nghiệm đánh giá hiệu quả sử dụng đạm, với các nghiệm thức khác nhau về nguồn phân, liều lượng, thời điểm và phương pháp bón, nhằm xác định ảnh hưởng đến năng suất và chất lượng dinh dưỡng của hạt. Nguồn: Gustavo Roa, nghiên cứu sinh sau đại học, Đại học Bang Kansas.
Quản lý phân bón (Hình 2) là một trong những biện pháp nông học chủ yếu nhằm nâng cao giá trị dinh dưỡng của cây trồng thực phẩm. Trong khi các nguyên tố đa lượng như đạm, lân và kali chủ yếu được sử dụng để tăng năng suất, thì việc sử dụng cân đối các nguyên tố này cũng ảnh hưởng đáng kể đến khả năng hấp thu và phân bố các nguyên tố vi lượng trong cây.
Đạm, nguyên tố thiết yếu cho quá trình quang hợp và tổng hợp protein, gián tiếp làm tăng hàm lượng kẽm và sắt trong hạt thông qua việc kích thích phát triển hệ rễ, làm chậm quá trình già hóa và kéo dài giai đoạn tích lũy vật chất vào hạt ở cây lúa mì (Hình 3) (Miner et al., 2022).
Bón lân góp phần cải thiện chất lượng dinh dưỡng bằng cách thúc đẩy sự phát triển của rễ và tăng tính di động của kẽm và sắt trong đất, từ đó tăng cường khả năng hấp thu và tích lũy các nguyên tố này trong hạt. Việc cung cấp đủ lân đã được chứng minh có liên quan đến hàm lượng kẽm cao hơn trong hạt ngô và lúa mì trồng trên đất thiếu lân (Zhang et al., 2012; Sánchez-Rodríguez et al., 2021).

Hình 3. Bón urê trên mặt đất cho cây lúa mì trong thí nghiệm đánh giá hiệu quả sử dụng đạm, nhằm tìm hiểu cách quản lý phân bón không chỉ giúp tăng năng suất, mà còn ảnh hưởng đến chất lượng dinh dưỡng của hạt thông qua tác động lên quá trình hấp thu và phân bố dinh dưỡng trong cây. Nguồn: Sofia Cominelli, nghiên cứu sinh sau đại học, Đại học Bang Kansas.
Kali giữ vai trò quan trọng trong vận chuyển carbohydrate và hoạt hóa enzyme, qua đó hỗ trợ gián tiếp quá trình vận chuyển vi chất dinh dưỡng và tổng hợp protein. Các nghiên cứu ngoài đồng cho thấy bón kali cân đối giúp cải thiện hiệu quả sử dụng đạm và nâng cao chất lượng protein của hạt, đồng thời tăng tích lũy vi chất trong các loại ngũ cốc (Guo et al., 2019; Römheld & Kirkby, 2010).
Việc bón trực tiếp vi lượng thường cần thiết để đạt được mức cải thiện đáng kể về hàm lượng dinh dưỡng trong hạt. Ví dụ, bổ sung kẽm qua đất hoặc phun qua lá đã làm tăng ổn định hàm lượng kẽm trong hạt đậu nành và ngô, ngay cả khi năng suất không tăng, cho thấy chất lượng dinh dưỡng có thể được cải thiện độc lập với năng suất (Lamb & Nelson, 2015). Ngược lại, bón sắt cho kết quả không nhất quán. Các nghiên cứu tại Kansas và vùng đồng bằng trung tâm Hoa Kỳ cho thấy phun sắt qua lá trên cây đậu nành đôi khi làm giảm năng suất do gây cháy lá, trong khi ở lúa mì, năng suất cao hơn thường đi kèm với hàm lượng sắt trong hạt thấp hơn, hiện tượng này được gọi là “hiệu ứng pha loãng” (Ruiz Diaz, 2013; Miner et al., 2022). Những kết quả này cho thấy rằng tăng cường sắt trong cây trồng đòi hỏi quản lý dinh dưỡng tổng hợp, đồng thời xem xét cẩn trọng tình trạng đất, loại cây trồng và tương tác giữa các nguyên tố dinh dưỡng.
Đất và vùng rễ
Hiểu rõ mối tương tác giữa đất và vùng rễ là yếu tố cốt lõi để duy trì sức khỏe đất, tối ưu hóa quá trình tái chế dinh dưỡng, quản lý đất hợp lý và cuối cùng là cải thiện khả năng hấp thu dinh dưỡng của cây trồng (Ghimire et al., 2024). Các đặc tính vật lý, hóa học và sinh học của đất quyết định độ phì nhiêu và khả năng cung cấp dinh dưỡng cho cây. Về mặt vật lý, các yếu tố như thành phần cơ giới, kích thước hạt và thành phần khoáng chất của đất ảnh hưởng đến khả năng giữ và trao đổi dinh dưỡng. Những loại đất giàu sét và chất hữu cơ thường giữ được nhiều cation dinh dưỡng như kali, canxi và magiê (Mengel et al., 2001).
Kết cấu và độ xốp của đất ảnh hưởng đến sự di chuyển của các chất dinh dưỡng đến bề mặt rễ. Các ion có độ di động cao như nitrat, sunfat, clorua và axit boric chủ yếu được vận chuyển bằng dòng khối, trong khi các nguyên tố ít di động hơn như phốt pho và đôi khi là kali chủ yếu di chuyển bằng khuếch tán (Halvin et al., 2005). Ngoài ra, độ pH của đất cũng điều chỉnh khả năng hấp thu dinh dưỡng của cây. Ví dụ, đất chua hạn chế sự hấp thu phốt pho, canxi và magiê, trong khi đất kiềm lại làm giảm khả năng hấp thu sắt, kẽm và mangan (Marschner, 2011).
Việc sử dụng nấm rễ cộng sinh và vi khuẩn kích thích sinh trưởng thực vật giúp gia tăng đa dạng hệ vi sinh vật vùng rễ, cải thiện tính sẵn có và khả năng hấp thu dinh dưỡng, qua đó nâng cao chất lượng dinh dưỡng của cây trồng. Nhiều nghiên cứu đã chứng minh rằng việc chủng nấm rễ cộng sinh và vi khuẩn có lợi giúp tăng hàm lượng vitamin, các loại axit hữu cơ và cải thiện chất lượng quả ở cây dâu tây và cà chua (Bona et al., 2015, 2017).

Hiểu rõ mối tương tác giữa đất và vùng rễ là điều cần thiết để duy trì sức khỏe đất, tối ưu hóa quá trình tái chế dinh dưỡng và quản lý đất, đồng thời tăng khả năng hấp thu và tính sẵn có của dinh dưỡng trong cây trồng. Hình minh họa được điều chỉnh từ Hình 2 trong bài “Soil Microbiome: Diversity, Benefits and Interactions with Plants” của Chauhan và cs. (2023) theo giấy phép CC BY 4.0.
Các biện pháp bổ sung hữu cơ như phân chuồng, phân xanh, lớp phủ thực vật và cây che phủ đã cho thấy tiềm năng lớn trong việc cải thiện giá trị dinh dưỡng của cây trồng. Chẳng hạn, Hunter và cs. (2011) báo cáo rằng các loại thực phẩm có nguồn gốc thực vật được trồng theo phương pháp canh tác hữu cơ có hàm lượng vi chất dinh dưỡng cao hơn so với phương pháp canh tác truyền thống. Một tổng quan gần đây cho thấy việc sử dụng các nguồn phân hữu cơ này làm tăng đáng kể hàm lượng sắt và kẽm trong hạt ngô (Manzeke-Kangara et al., 2023). Ngoài ra, các phương pháp phủ đất khác nhau cũng được ghi nhận là giúp cải thiện chất lượng quả và giá trị dinh dưỡng ở cây dâu tây (Atkinson et al., 2006). Than sinh học gần đây cũng nhận được nhiều sự quan tâm của nông dân, nhờ khả năng tăng năng suất và nâng cao chất lượng dinh dưỡng của cây trồng (Lei et al., 2024). Những kết quả này cho thấy bổ sung hữu cơ là một công cụ đầy triển vọng trong việc nâng cao giá trị dinh dưỡng của cây trồng.
Hơn nữa, Viện Hàn lâm Khoa học, Kỹ thuật và Y học Hoa Kỳ (NASEM, 2024) cũng đã xác định việc nghiên cứu mối liên kết giữa sức khỏe đất và sức khỏe con người là ưu tiên hàng đầu, thúc đẩy các nghiên cứu về hệ vi sinh vật đất nhằm cải thiện sức khỏe đất, chất lượng thực phẩm và sức khỏe con người.
Phun phân qua lá
Phun phân qua lá là một biện pháp quản lý dinh dưỡng hiệu quả, trong đó liều lượng, thời điểm và giai đoạn sinh trưởng của cây trồng đóng vai trò then chốt để đạt hiệu quả hấp thu tối ưu (Fernandez & Eichert, 2009). Trong những điều kiện mà đất hạn chế khả năng cung cấp dinh dưỡng, hoặc khi phân tích mô và triệu chứng sinh lý cho thấy thiếu hụt dinh dưỡng, phương pháp này có thể được sử dụng để bổ sung kịp thời các nguyên tố thiết yếu (Rajasekar et al., 2017). Phun qua lá đặc biệt hữu ích đối với các nguyên tố vi lượng, nhờ khả năng hấp thu nhanh qua biểu bì lá, nhất là trong các điều kiện đất có pH cao hoặc ẩm độ quá mức, gây hạn chế hấp thu qua rễ.
Hiệu quả của phương pháp phun phân qua lá phụ thuộc vào thời điểm phun, điều kiện môi trường, giai đoạn sinh trưởng của cây và tình trạng sinh lý chung. Thời điểm phun tối ưu thường là sáng sớm hoặc chiều muộn, khi nhiệt độ mát và độ ẩm vừa phải giúp tăng tính thấm của lá và cải thiện khả năng hấp thu dinh dưỡng (Oosterhuis, 2009). Biện pháp này đặc biệt hiệu quả khi thực hiện vào các giai đoạn sinh trưởng quan trọng như giai đoạn đổ hạt hoặc phát triển quả, giúp nâng cao giá trị dinh dưỡng của sản phẩm thu hoạch (Jalal et al., 2023). Ví dụ, phun đạm qua lá có thể tăng hàm lượng protein trong hạt lúa mì (Turley et al., 2001; Dick et al., 2016).
Theo Jalali và cs. (2022), phun qua lá các chất kích thích sinh trưởng tự nhiên như chiết xuất rong biển kết hợp với vi lượng giúp tăng năng suất và chất lượng dinh dưỡng của quả cà chua. Nhiều nghiên cứu khác cũng ghi nhận rằng phun qua lá các nguyên tố như i-ốt, silic, kẽm và sắt làm tăng hàm lượng các nguyên tố này trong hạt và quả (Budke et al., 2021; Hao et al., 2021; Lu et al., 2024). Do đó, phun qua lá vi lượng và chất kích thích sinh trưởng sinh học được xem là một hướng tiềm năng đầy hứa hẹn trong việc nâng cao giá trị dinh dưỡng của cây trồng thực phẩm.
Nông nghiệp chính xác
Với sự phát triển của các công cụ nông nghiệp chính xác, cảm biến, máy bay không người lái và hệ thống hỗ trợ ra quyết định đã được ứng dụng rộng rãi trong quản lý dinh dưỡng và canh tác cây trồng. Việc phát hiện sớm tình trạng thiếu ẩm và thiếu hụt các nguyên tố dinh dưỡng đa, vi lượng thông qua các công nghệ cảm biến từ xa và thiết bị bay không người lái giúp tưới tiêu và bón phân chính xác hơn, đảm bảo cây hấp thu nước và dinh dưỡng hiệu quả, đặc biệt là trong các giai đoạn sinh trưởng quan trọng như đổ hạt và phát triển quả.

Hình 4. Thí nghiệm đánh giá hiệu quả sử dụng đạm trên cây lúa miến nhằm xác định ảnh hưởng của biện pháp quản lý phân bón đến năng suất và chất lượng dinh dưỡng của hạt thông qua quá trình hấp thu và phân bố dinh dưỡng trong cây. Nguồn: Sofia Cominelli.
Quản lý nước là yếu tố then chốt trong việc tối ưu hóa năng suất và chất lượng nông sản. Cảm biến độ ẩm đất cung cấp dữ liệu liên tục về tình trạng nước trong vùng rễ, yếu tố có mối liên hệ trực tiếp với năng suất cây trồng (Cominelli et al., 2024). Việc ứng dụng cảm biến này trong sản xuất cà chua giúp tăng năng suất và chất lượng quả nhờ xác định chính xác nhu cầu nước của cây (El Chami et al., 2023; He et al., 2024). Tương tự, quản lý tưới tiêu dựa trên cảm biến ở nho giúp cải thiện chất lượng quả đồng thời tiết kiệm nước (Garofalo et al., 2023). Bên cạnh đó, công nghệ viễn thám đa phổ và hồng ngoại nhiệt hỗ trợ xác định nhu cầu nước ở các giai đoạn sinh trưởng quan trọng, từ đó nâng cao chất lượng quả bưởi (Bellvert et al., 2016; Jewan et al., 2024).
Nông nghiệp chính xác còn góp phần tối ưu hóa dinh dưỡng (Hình 4) thông qua cải thiện thời điểm, vị trí và liều lượng bón phân dựa trên dữ liệu thực địa theo thời gian thực. Các nền tảng hỗ trợ ra quyết định tích hợp thông tin cảm biến, bản đồ năng suất và mô hình sinh trưởng cây trồng để định hướng các biện pháp canh tác giúp nâng cao cả năng suất lẫn giá trị dinh dưỡng (Gebbers & Adamchuk, 2010; Xing & Wang, 2024). Kết hợp với tưới tiêu chính xác, những công cụ này cho phép đồng bộ hóa việc cung cấp nước và dinh dưỡng, nâng cao hiệu quả hấp thu trong các giai đoạn sinh trưởng quan trọng. Ngoài ra, máy bay không người lái (UAV) cũng là phương tiện hiệu quả trong việc cung cấp dinh dưỡng và chất kích thích sinh trưởng. Ví dụ, Xu và cs. (2021) cho biết phân kẽm dạng chelate phun bằng UAV giúp tăng hàm lượng kẽm trong hạt lúa, đồng thời mang lại phương pháp bón phân an toàn, hiệu quả và tiết kiệm chi phí.
Kết luận và định hướng tương lai
Nâng cao giá trị dinh dưỡng của cây trồng thực phẩm là trọng tâm trong việc giải quyết nạn đói tiềm ẩn và cải thiện sức khỏe toàn cầu. Việc cải thiện dinh dưỡng thành công đòi hỏi hiểu biết tích hợp về sinh lý học thực vật, từ cấu trúc hệ rễ và quá trình hấp thu dinh dưỡng, đến vận chuyển qua hệ mạch và cơ chế tích lũy vào hạt. Ứng dụng tổng hợp các biện pháp canh tác, bao gồm quản lý phân bón chính xác, cải thiện sức khỏe đất, phun phân qua lá, và công nghệ nông nghiệp chính xác, mang lại giải pháp nhanh chóng, có thể mở rộng quy mô, giúp nâng cao chất lượng nông sản, đồng thời xây dựng hệ thống canh tác bền vững và linh hoạt, mang lại lợi ích cho cả người sản xuất và người tiêu dùng.
Trong tương lai, nghiên cứu cần tập trung vào phát triển các hệ thống cung cấp dinh dưỡng thông minh, kết hợp cảm biến dinh dưỡng theo thời gian thực trong đất và cây với công nghệ bón phân định hướng và nông nghiệp số. Việc khai thác mối liên kết giữa sức khỏe đất - cây trồng - con người thông qua các tiếp cận liên ngành sẽ là nền tảng để phát triển chiến lược tăng cường dinh dưỡng bền vững.
Bên cạnh đó, việc mở rộng các đổi mới này trong nhiều điều kiện môi trường khác nhau, đồng thời đảm bảo khả năng ứng dụng và chi phí phù hợp cho nông dân, vẫn là yếu tố then chốt. Cuối cùng, gắn kết giữa sức khỏe đất, dinh dưỡng cây trồng và sức khỏe con người sẽ mở ra cơ hội mang tính đột phá nhằm giảm thiểu khủng hoảng dinh dưỡng và tăng cường khả năng chống chịu của hệ thống lương thực toàn cầu. Để đạt được mục tiêu này, cần có sự đầu tư đáng kể và cam kết dài hạn từ chính phủ và các tổ chức tài trợ, đặc biệt khi việc cải thiện dinh dưỡng của cây trồng chịu ảnh hưởng bởi nhiều yếu tố môi trường đa dạng.
Huỳnh Thị Đan Anh theo Agronomy.
Số lần xem: 265












